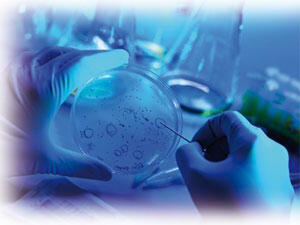
culture cellulaire

Télomères, télomérase et vieillissement L'astragaloside IV, un activateur de la télomérase
 Dans
la littérature scientifique, l'implication de la télomérase
dans l'immortalité cellulaire est maintenant bien établie.
En laboratoire, dans les boîtes de Pétri, l'introduction de
télomérase dans des cultures cellulaires humaines transforme
des cellules qui autrement seraient mortelles en cellules immortelles.
Dans
la littérature scientifique, l'implication de la télomérase
dans l'immortalité cellulaire est maintenant bien établie.
En laboratoire, dans les boîtes de Pétri, l'introduction de
télomérase dans des cultures cellulaires humaines transforme
des cellules qui autrement seraient mortelles en cellules immortelles.
À la suite de ces découvertes, quelques petites molécules
activatrices de la télomérase ont été développées
pour être utilisées dans le traitement du vieillissement cellulaire.
Certaines sont extraites de l'astragale (Astragalus membranaceus).
Les télomères, du grec telos (fin)
et meros (partie) constituent la structure coiffant l'extrémité du
double brin d'ADN des chromosomes. Ils sont constitués de séquences
nucléotidiques répétées, de type TTAGGG, allant
de un à quelques dizaines de kilobase(s). Ces séquences télomériques
protègent le génome d'une perte d'information due à un
raccourcissement progressif des chromosomes à chaque division cellulaire.
Elles protègent également les extrémités naturelles
des chromosomes contre les fusions bout à bout et les recombinaisons
qui pourraient être provoquées par les systèmes de réparation
de l'ADN.
Le rôle des télomères a été deviné dès
les années 1930 mais ce n'est que dans les années 1980 que ce
mécanisme de protection a été décrypté.
De nombreuses études ont montré que la longueur des télomères
présents dans les lymphocytes humains raccourcit progressivement avec
le passage des années. Les télomères les plus courts sont
observés chez les octogénaires (4 000 à 6 000
paires de bases) alors que chez les nouveau-nés, la longueur des télomères
oscille entre 8 000 et 12 000 pb.
En fait, l'ADN d'un télomère se raccourcit à chaque division
cellulaire, car la réplication des extrémités d'une molécule
d'ADN linéaire est incomplète. Lorsque les télomères
atteignent de cette façon une taille critique, la cellule entre en sénescence.
Les télomères agissent comme une horloge biologique régissant
la durée de vie des cellules. C'est le biologiste russe Alekseï Olovnikov
qui a pour la première fois émis l'hypothèse que la durée
de vie maximale des cellules en culture (limite de Hayflick) est corrélée à la
perte progressive de séquences télomériques. Cette théorie
est connue sous le nom de théorie télomérique du vieillissement.
En 1985, Elisabeth Blackburn, Carol Greider et Jack Szostak identifient la
télomérase. C'est une enzyme de type transcriptase* inverse,
capable d'inverser ce processus de dégradation des télomères.
Leur travail est récompensé en 2009 par un prix Nobel de physiologie
et médecine. Les télomérases assurent la synthèse
et la croissance des télomères1. La télomérase
a d'autres fonctions, découvertes plus récemment. Elle intervient
notamment dans la prolifération, la protection contre l'apoptose, la
différenciation ou la réparation de l'ADN.
* Une transcriptase inverse est une enzyme permettant la synthèse de l'ADN à partir de l'ARN.
La télomérase n'est pas active dans toutes les cellules
La
question d'un rôle éventuel du raccourcissement des chromosomes
dans le vieillissement est soulevée pour la première fois en
1986 par Howard Cooke, chercheur au Medical Research Council de Cambridge.
Il mesure, et c'est une première, les télomères présents à l'extrémité de
chromosomes humains. Examinant les télomères des chromosomes
sexuels, il s'aperçoit qu'ils sont plus longs dans les cellules germinales
que dans celles des autres tissus de l'organisme ou, en d'autres termes, dans
les cellules somatiques (terme provenant du grec sômatikos, du corps).
Cook suppose que la télomérase, récemment identifiée,
n'est peut-être pas active dans les cellules somatiques humaines normales.
Une érosion de leur ADN télomérique expliquant dans ce
cas le raccourcissement qu'il a auparavant observé dans des cellules
sanguines.
La
question d'un rôle éventuel du raccourcissement des chromosomes
dans le vieillissement est soulevée pour la première fois en
1986 par Howard Cooke, chercheur au Medical Research Council de Cambridge.
Il mesure, et c'est une première, les télomères présents à l'extrémité de
chromosomes humains. Examinant les télomères des chromosomes
sexuels, il s'aperçoit qu'ils sont plus longs dans les cellules germinales
que dans celles des autres tissus de l'organisme ou, en d'autres termes, dans
les cellules somatiques (terme provenant du grec sômatikos, du corps).
Cook suppose que la télomérase, récemment identifiée,
n'est peut-être pas active dans les cellules somatiques humaines normales.
Une érosion de leur ADN télomérique expliquant dans ce
cas le raccourcissement qu'il a auparavant observé dans des cellules
sanguines.
Au début des années 1990, une relation très importante
est observée entre les capacités prolifératives des cellules
primaires humaines (des cellules fraîchement prélevées
sur un organisme ayant généralement une durée de vie limitée)
en culture et la longueur de leurs télomères. Plus leurs télomères
sont longs et plus le nombre de divisions cellulaires effectuées par
la cellule est important.
Télomères, télomérase et vieillissement
 Les
cellules normales, contrairement aux lignées cellulaires tumorales,
ne se divisent pas indéfiniment. La limite des capacités de prolifération
conduit à un arrêt permanent du cycle cellulaire par un processus
appelé sénescence réplicative. Cette sénescence
aurait des effets secondaires nuisibles contribuant aux perturbations que l'on
voit progressivement apparaître avec le vieillissement.
Les
cellules normales, contrairement aux lignées cellulaires tumorales,
ne se divisent pas indéfiniment. La limite des capacités de prolifération
conduit à un arrêt permanent du cycle cellulaire par un processus
appelé sénescence réplicative. Cette sénescence
aurait des effets secondaires nuisibles contribuant aux perturbations que l'on
voit progressivement apparaître avec le vieillissement.
La formation de l'organisme se fait, au cours du développement embryonnaire, à travers
un grand nombre de divisions cellulaires pour lesquelles l'intervention de
la télomérase est indispensable. Cette enzyme, composée
d'une protéine et d'un ARN, reconstitue l'extrémité des
chromosomes. Elle est activée pendant tout le développement fœtal
et protège les télomères durant cette période vitale
de l'expansion cellulaire.
Mais, comme Cook le supposait, la plupart des cellules somatiques de l'homme
ne possèdent pas de télomérase active. Dès la naissance2,
on observe dans la plupart des tissus une réduction de l'expression
de la télomérase. La télomérase est présente
dans les cellules de la lignée germinale et dans certaines cellules
souches somatiques mais est absente ou en très faible quantité dans
la plupart des cellules somatiques adultes. On détecte une activité de
la télomérase dans les cellules sexuelles.
Toutes les cellules souches somatiques adultes semblent capables d'activer
la télomérase au cours de la régénération
de tissus. Mais ces périodes d'activation sont insuffisantes pour prévenir
la perte de télomère corrélée à une diminution
de la capacité d'activer la télomérase au cours du vieillissement
et en cas de stress. De plus, ce dernier peut accélérer la perte
de télomère en accroissant le renouvellement cellulaire et la
quantité de télomère perdue par division cellulaire.
L'implication du stress sur l'activité de la télomérase
En 2004, une étude3 avait montré que le stress chronique a également un effet sur la longueur des télomères. Une étude plus récente explique de quelle façon cela se produit. Des chercheurs de l'université de Californie, à Los Angeles, ont étudié des lymphocytes provenant de donneurs sains (hommes et femmes) âgés de 25 à 55 ans. Les cellules ont été traitées avec différentes concentrations de cortisol, l'hormone libérée par l'organisme lorsqu'il est soumis à un stress, ou avec du DMSO (comme témoin). Au bout de trois jours, les cultures traitées avec du cortisol avaient moins de cellules que les cultures témoin. Alors que le traitement avec une concentration de cortisol équivalente à celle trouvée normalement chez l'homme n'avait aucun effet sur l'activité de la télomérase, des concentrations comparables à celles retrouvées dans un organisme soumis au stress ont réduit l'activité de la télomérase jusqu'à 50 % par rapport à celle mesurée dans les cultures témoin. Cette découverte explique de quelle façon le stress réduit la télomérase, accélérant ainsi le vieillissement cellulaire à travers un accroissement de la production du cortisol. Le Dr Effros, l'un des chercheurs auteurs de cette étude, expliquait : « Lorsque le corps est soumis à un stress, il stimule la production de cortisol pour soutenir une réponse à ce stress qui affaiblit le système immunitaire. Nous testons des voies thérapeutiques pour renforcer le niveau de télomérase afin d'aider le système immunitaire à se protéger des effets du cortisol. Si nous y parvenons, un jour une pilule pourrait être créée pour renforcer la capacité du système immunitaire à supporter un stress émotionnel chronique. »

Le raccourcissement des télomères a été étudié sur
des cultures de cellules humaines, dans des maladies génétiques
présentant une mutation de la télomérase et sur des modèles
animaux de déficience en télomérase. Une usure constante
des télomères est observée in vitro dans les cultures
cellulaires sénescentes (de 40 à 200 nucléotides par division)
ou in vivo dans les tissus humains au cours du vieillissement de l'organisme
(de 15 à 50 nucléotides par an). Chez la levure, cette relation
entre un raccourcissement des télomères et la sénescence
cellulaire avait été démontrée : en inactivant
le système d'entretien des télomères, on imposait aux
cellules une durée de vie limitée.
Ces études soulignent une relation de cause à effet entre la
perte de télomère, le vieillissement cellulaire, la diminution
de la régénération cellulaire et la perte de fonction
et de structure tissulaires. Des études épidémiologiques
viennent soutenir cette relation de cause à effet en montrant, chez
l'homme, que des télomères courts sont des facteurs de risque
d'athérosclérose, d'hypertension, de maladie cardio-vasculaire,
d'Alzheimer, d'infections, de diabète, de fibrose, de syndrome métabolique,
de cancers et influent sur la mortalité globale.
La longueur des télomères a été analysée
chez 150 personnes âgées de 60 ans et plus4. Celles
qui possédaient les télomères les plus courts avaient
une probabilité huit fois supérieure de mourir de maladie infectieuse
et trois fois supérieure d'avoir une crise cardiaque. Les auteurs de
l'étude expliquent ces résultats par le fait que les cellules
immunitaires doivent se répliquer rapidement pour lutter contre une
infection. Or, le raccourcissement des télomères entraînerait
un ralentissement de la réplication, augmentant ainsi le risque d'infections.
Les télomères humains sont programmés pour se raccourcir
d'environ 100 paires de bases par division cellulaire. Lorsque la perte totale
atteint plusieurs milliers de bases, les cellules cessent de se diviser et
entrent en sénescence.
Télomérase et cancers
 Le
cancer est défini par l'immortalisation acquise de cellules dont la
prolifération forme la tumeur primitive puis les métastases qui
vont coloniser les autres tissus. Dans ces cellules tumorales, plusieurs mécanismes
concourent à la réactivation de la télomérase et,
par suite, au rallongement de l'extrémité des chromosomes. À la
différence des cellules normales qui arrêtent de se diviser et
entrent en sénescence, les cellules cancéreuses peuvent se diviser
indéfiniment et sont décrites comme immortelles.
Le
cancer est défini par l'immortalisation acquise de cellules dont la
prolifération forme la tumeur primitive puis les métastases qui
vont coloniser les autres tissus. Dans ces cellules tumorales, plusieurs mécanismes
concourent à la réactivation de la télomérase et,
par suite, au rallongement de l'extrémité des chromosomes. À la
différence des cellules normales qui arrêtent de se diviser et
entrent en sénescence, les cellules cancéreuses peuvent se diviser
indéfiniment et sont décrites comme immortelles.
Alors, une question doit être posée : l'introduction de télomérase
dans des cellules saines pourrait-elle les rendre malignes ?
Selon des études publiées à la fin de 1999 dans le mensuel
Nature Genetics5, il apparaît que non. Woodring Wright, de
l'université du Texas, l'un des auteurs de ces travaux, a déclaré : « Nous
démontrons clairement que l'ajout de télomérase dans des
cellules humaines en culture ne provoque pas leur évolution en cellules
cancéreuses. » Au cours de ces travaux, l'équipe du Dr
Wright est parvenue, en laboratoire, à multiplier des cellules humaines
plus de deux cents fois au-delà de leur espérance normale de
vie, sans provoquer l'apparition de cellules cancéreuses. Ces cellules
semblent indifférenciables des « jeunes cellules » et ne
montrent aucun signe d'anomalie chromosomique ni d'aberration des points de
contrôle du cycle cellulaire. Dans une étude parallèle,
l'équipe du Dr Choy-Pik Chiu, de la société californienne
Geron corporation, a constaté que l'ajout de télomérase
dans des cellules de souris ne provoquait pas de tumeurs malignes. Pour le
Dr Wright, les anomalies observées dans les cellules cancéreuses
sont dues à d'autres mutations, la télomérase permet simplement
aux cellules de continuer à se multiplier. La télomérase
ne semble donc pas oncogène.
Forcer l'expression de la télomérase
 La
plupart des cellules somatiques humaines n'expriment pas la télomérase
mais elles contiennent tous les autres composants de l'enzyme. La télomérase
est constituée d'une sous-unité catalytique, hTRT, et d'une sous-unité ribonucléique,
hTR. Cela veut dire que l'expression forcée de la sous-unité transcriptase
inverse de la télomérase humaine (hTRT) reconstitue l'activité de
la télomérase. Andrea Bodnar et son équipe, de Geron Corporation,
ont introduit le gène hTRT dans des cellules humaines primaires et ont étudié les
capacités de prolifération de ces cellules ainsi transformées.
Ils ont observé un allongement des séquences télomériques.
Le potentiel de croissance des cellules dotées de télomères
artificiellement allongés s'est modifié de façon spectaculaire.
Alors que des cellules primaires normales entrent en sénescence au bout
d'un nombre bien défini de divisions, les cellules exprimant la télomérase
ont continué de se diviser. Ces cellules primaires ont été cultivées
pendant plus d'un an sans qu'apparaisse de signe évident de transformation
cancéreuse. Elles ont conservé un caryotype normal et une morphologie
juvénile. Ces expériences ont été réalisées
sur des cellules de rétine, de prépuce et sur des cellules vasculaires.
Les résultats ont été identiques sur ces trois types de
cellules, laissant supposer que le raccourcissement des télomères
joue un rôle universel dans la sénescence des cellules de l'homme6.
La
plupart des cellules somatiques humaines n'expriment pas la télomérase
mais elles contiennent tous les autres composants de l'enzyme. La télomérase
est constituée d'une sous-unité catalytique, hTRT, et d'une sous-unité ribonucléique,
hTR. Cela veut dire que l'expression forcée de la sous-unité transcriptase
inverse de la télomérase humaine (hTRT) reconstitue l'activité de
la télomérase. Andrea Bodnar et son équipe, de Geron Corporation,
ont introduit le gène hTRT dans des cellules humaines primaires et ont étudié les
capacités de prolifération de ces cellules ainsi transformées.
Ils ont observé un allongement des séquences télomériques.
Le potentiel de croissance des cellules dotées de télomères
artificiellement allongés s'est modifié de façon spectaculaire.
Alors que des cellules primaires normales entrent en sénescence au bout
d'un nombre bien défini de divisions, les cellules exprimant la télomérase
ont continué de se diviser. Ces cellules primaires ont été cultivées
pendant plus d'un an sans qu'apparaisse de signe évident de transformation
cancéreuse. Elles ont conservé un caryotype normal et une morphologie
juvénile. Ces expériences ont été réalisées
sur des cellules de rétine, de prépuce et sur des cellules vasculaires.
Les résultats ont été identiques sur ces trois types de
cellules, laissant supposer que le raccourcissement des télomères
joue un rôle universel dans la sénescence des cellules de l'homme6.
Réactiver la télomérase renverse les processus de vieillissement
Une récente étude7 sur des souris montre qu'en réactivant
la télomérase il serait possible de renverser un vieillissement
prématuré.
Lorsque des souris sont modifiées génétiquement pour manquer
totalement de télomérase, leurs télomères, en quelques
générations, deviennent progressivement plus courts. Ces animaux
vieillissent beaucoup plus rapidement que des souris normales. Elles sont insuffisamment
fertiles et souffrent de maladies liées au vieillissement telles que
le diabète, l'ostéoporose ou la neurodégénération.
Elles meurent également jeunes. Pour le Dr DePinho, ces données
suggèrent l'idée que la perte de télomérase pourrait être
un instigateur très important du processus de vieillissement.
Pour regarder si ces effets pouvaient être réversibles, l'équipe
du Dr DePinho a programmé des souris de telle sorte que la télomérase
inactivée puisse être réactivée en nourrissant les
animaux avec un produit chimique appelé 4-OHT. Les chercheurs ont laissé les
animaux grandir jusqu'à l'âge adulte sans la télomérase
que l'on a réactivée ensuite pendant un mois. Ils ont évalué la
santé des animaux un mois plus tard.
Les résultats ont été étonnants ! Les testicules
ratatinés sont revenus à la normale et les animaux ont retrouvé leur
fertilité. D'autres organes, comme la rate, le foie ou les reins, ont
récupéré de leur stade dégénéré.
La stimulation de la télomérase pendant un mois a également
inversé les effets du vieillissement dans le cerveau. Les animaux dont
l'activité de la télomérase a été restaurée
avaient des cerveaux nettement plus gros que ceux manquant toujours de l'enzyme.
Les cellules neurales qui produisent de nouveaux neurones et soutiennent les
cellules cérébrales, ont recommencé à travailler.
Pour le Dr DePinho, ces résultats font penser qu'il y aurait un point
de retour pour les troubles associés au vieillissement. Des médicaments
augmentant l'activité de la télomérase valent la peine
d'être développés comme traitement potentiel des rares
maladies caractérisées par un vieillissement prématuré et,
pourquoi pas, pour le traitement des pathologies liées couramment au
vieillissement.
Lorsque la question de la présence de télomérase dans
les tumeurs est abordée, le Dr DePinho souligne que la télomérase
devrait au contraire empêcher les cellules normales de devenir cancéreuses,
essentiellement en prévenant les dommages sur l'ADN.
Les extraits d'astragale (Astragalus membranaceus)
 L'astragale
est utilisé comme fortifiant et pour renforcer la fonction immunitaire
par la médecine traditionnelle chinoise depuis des centaines d'années.
L'astragale contient entre autres une série de glycosides triterpène
cycloartane dénommés astragalosides I à VIII.
L'astragale
est utilisé comme fortifiant et pour renforcer la fonction immunitaire
par la médecine traditionnelle chinoise depuis des centaines d'années.
L'astragale contient entre autres une série de glycosides triterpène
cycloartane dénommés astragalosides I à VIII.
Dans les années 1980, l'astragale est devenu extrêmement populaire
aux États-Unis à travers les médias comme stimulant du
système immunitaire. Aujourd'hui, la plupart des recherches pharmacologiques
portant sur l'astragale sont concentrées sur ses polysaccharides immunostimulants
et sur d'autres de ses ingrédients actifs utiles pour traiter des maladies
liées à des déficiences immunitaires.
L'astragaloside IV est présent en quantité infinitésimale
dans la racine d'astragale. Un procédé extrêmement complexe
permet de l'extraire et de le concentrer pour en obtenir une quantité active.
Ses propriétés ont été également largement étudiées
dans des centres de recherche en Europe et en Chine. C'est un anti-inflammatoire,
un antifibrotique et un antioxydant. Il est connu pour avoir des propriétés
cardio-protectrices et vasodilatatrices. Il est neuroprotecteur et protège
le myocarde contre l'ischémie/reperfusion. Aucun effet secondaire n'a été rapporté au
cours des différentes études.
L'extrait d'astragale agit sur l'activité de la télomérase
Une étude8 pilote récemment publiée
a examiné les effets d'un extrait d'Astragalus membranaceus, activateur
de la télomérase, développé et breveté par
Geron Corporation. Cette étude a duré un an. Les sujets ont reçu
un « pack » de suppléments nutritionnels en plus
de l'activateur de la télomérase.
L'activité de la télomérase a été mesurée
dans des cultures de kératinocytes et de fibroblastes des sujets. Les
résultats ont montré que l'extrait breveté active modérément
la télomérase dans les kératinocytes, les fibroblastes
et les cellules immunitaires en culture. Dans un sous-groupe de sujets, la
distribution de la longueur des télomères dans les leucocytes
a été mesurée au début de l'étude et au
bout de douze mois. Bien que la longueur moyenne des télomères
n'ait pas augmenté, une réduction significative du pourcentage
de télomères courts a été observée.
L'astragale a une action immunomodulatrice
L'astragale stimule le système immunitaire de différentes
façons. Il augmente le nombre de cellules souches dans la moelle osseuse
et le tissu lymphatique, et favorise leur développement en cellules
immunitaires actives. Il semble aider à faire passer les cellules immunitaires
d'un stade de « repos » à une très grande
activité. Il aide également l'organisme à produire de
l'immunoglobuline et stimule les macrophages. L'astragale peut également
aider à activer les cellules naturelles tueuses et les lymphocytes T9.
Chez des souris, des doses orales d'Astragalus stimulent plusieurs aspects
de l'immunité. On a montré que les polysaccharides de l'Astragalus
potentialisent l'activité antitumorale des interleukines-2 et l'activité des
monocytes, ils améliorent la réponse des lymphocytes de sujets
normaux et de patients cancéreux10, renforcent l'activité des
cellules naturelles tueuses chez des sujets normaux et chez des patients souffrant
d'un lupus systémique érythémateux11. La fraction
F3 des polysaccharides potentialise l'activité de cellules immunitaires
de patients cancéreux ou sidéens.
On a également montré que les polysaccharides de l'astragale
induisent, chez l'animal comme chez l'homme, la production endogène
d'interféron et potentialisent ses actions dans les infections virales.
Des souris prétraitées avec de l'astragale puis exposées
au virus Coxsachie B3, au virus japonais de l'encéphalite ou virus Sendai,
ont des niveaux d'interféron et une production de macrophages significativement
plus importants que ceux des animaux non prétraités.
On a montré que l'astragale augmente la résistance aux effets
immunosuppresseurs des médicaments de chimiothérapie, tout en
stimulant la production par les macrophages d'interleukine-6 et de facteur
nécrosant des tumeurs12.
L'astragale a des propriétés bénéfiques
pour le système cardio-vasculaire
Des principes actifs de l'astragale ont des effets bénéfiques
sur la fonction cardiaque parce qu'ils inhibent la formation de lipides oxydés
dans le myocarde et diminuent la coagulation sanguine13.
Des études ont montré que l'extrait d'astragale a des effets
cardiotoniques, probablement en raison de son pouvoir antioxydant. On a injecté quotidiennement
pendant deux semaines à des patients souffrant d'insuffisance cardiaque
congestive, de l'astragaloside IV extrait d'astragale. Cela a nettement amélioré leur état.
Au bout de deux semaines, les symptômes de douleur à la poitrine
et la dyspnée ont été soulagés chez la plupart
des sujets de l'étude. Le fonctionnement du ventricule cardiaque gauche
a également été amélioré14. Dans
d'autres études, l'astragale a montré des effets bénéfiques
sur des sujets souffrant d'angine de poitrine15.
-----------------------------------------------------------------------------------------------------------------------------------------------
Références :
1. Blackburn E. H. et al., Telomeres and telomerase. The path from maize,
tetrahymena and yeast to human cancer and aging. Nat. Med. 2006 ; 12 :
1133-1138.
2. Wright D. L. et al., Characterization of telomerase activity in the human
ovocyte and preimplantation embryo. Mol. Hum. Reprod. 2001 ; 7 :
947-955.
3. Epel E. S. et al,. Accelerated telomere shortening in response to life stress.
Proc. Natl. Acad. Sci. USA 2004 ; 101 : 17312-17315.
4. Cawthon R. M. et al., Association between telomere length in blood and mortality
in people aged 60 years or older. Lancet 2003 ; 361 : 359-395.
5. Jiang X. R. et al., Telomerase expression in human somatic cells does not
induce changes associated with a transformed phenotype. Nat. Genet. 1999 ;
21 : 111-114.
6. Bodnar A. G. et al. Extension of life span by introduction of telomerase
into normal human cells. Science 1998 ; 279 : 349-52.
7. DePinho R. A. et al. ,Telomerase activation reverses tissue degeneration
in aged telomere-deficient mice. Nature 469, 102-106, January 2010. Published
online 28 November 2010.
8. Harley Calvin B. et al., A natural product telomerase activator as part
of a health maintenance program. Rejuvenation Research. Online ahead of print:
September 7, 2010. Doi: 10.1089/rej.2010.1085.
9. Jiao Y. et al., Influence of flavonoid of Astragalus membranaceus' system
and leaves on the function of cell mediated immunity in mice, Zhongguo Zhong
Xi Yi Jie He Za Zhi, 1999, 19:356-358.
10. Wang D.C., Influence of Astragalus membranaceus polysaccharide FB on immunologic
function of human periphery blood lymphocyte, Zhonghua Zhong Liu Za Zhi, 1989,
11:180-183.
11. Zhao X.Z., Effects of Astragalus membranaceus and Tripterygium hypoglancum
on natural killer cell activity of peripheral blood mononuclear in systemic
Lupus erythematosus, Zhonggo Zhong Xi Yi Jie He Za Zhi, 1992, 12:679-671.
12. Yoshida Y. et al., Immunomodulating activity of Chinese medicinal herbs
and Oldenlandia diffusa in particular, Int. J. Immunopharmacol., 1997, 19:359-370.
13. Pumova J. et al., Phytotherapeutic aspects of diseases of the cardiovascular
system. 5. Saponins and possibilities of their use in prevention and therapy.
Ceska Slov. Farm. 1995;44:246-251.
14. Luo H. M. et al., Nuclear cardiology study on effective ingredients of
Astragalus membranaceus in treating heart failure. Zhongguo Zhong Xi Yi Jie
He Za Zhi, 1995;15:77-80.
15. Lei Z. Y. et al. Action of Astragalus membranaceus on left ventricular
function of angine pectoris. Zhongguo Zhong Xi Yi Jie He Za Zhi, 1994;14: 199-202,
195.

Un complément d’astragaloside IV pour freiner le raccourcissement des télomères
test.supersmart.com
Une formule anti-âge synergique contenant du transresvératrol et des antioxydants d’exception
test.supersmart.comTous droits de reproduction réservés
Gratuit
Merci de votre visite, avant de partir
inscrivez-vous auClub SuperSmart
d'avantages exclusifs:
- Gratuit : la publication hebdomadaire scientifique "Nutranews"
- Des promotions exclusives aux membres du club



 Format PDF
Format PDF













